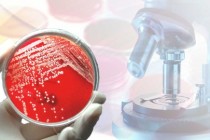

28岁的王静是大医院托管小医院的受惠者。今年2月,她在湖北洪湖市人民医院生下孩子后,出现了肺栓塞的症状,晕倒、呼吸困难、...

2013年末全国医疗卫生机构总数达97.44万个,增速为2.54%,主要是因为当年计划生育技术服务机构增加了原人口计生部...

与众多的互联网企业一样,医疗机构中的信息化系统同样面临着网络设备成本高、利用率低,安全风险大,传输瓶颈等问题,并且这些问...

前言:日前从市卫生部门获悉,目前,国家卫计委已批复,明确了以家庭病床、巡诊等方式开展的医疗服务,属于合法执业行为。

在微信和微博上与朋友比拼行走步数,用公众号和挂号平台挂号,或者直接通过电商平台购买药品快递到家……然后,我们还能用互联网...

今年发布的《国务院办公厅关于促进医药产业健康发展的指导意见》。

10月起,京津冀132家医疗机构对首批27项临床检验结果实施互认。

金秋十月,丹桂飘香。近日,“招商银行银医智慧医疗交流会”在杭州顺利召开。

随着人口老龄化形势的日益严峻,养老难问题也越来越受到关注。

在“互联网+”逆袭创新更具价值,还是“+互联网”顺势创新更为实用这些论调炒得热热闹闹的今天,各行各业都在努力搭上互联网这...

随着大数据、云计算、移动互联、人工智能等现代信息技术在健康医疗领域的广泛应用。
日前,国家卫生计生委日前印发通知,决定试行医学检验实验室基本标准和管理规范

10月25日,中共中央、国务院印发了《“健康中国2030”规划纲要》。

2016年的诺贝尔文学奖颁给了鲍勃。迪伦。一时间,众声喧哗,仿佛这是桩多么难以想象的事情。

最近,网文《马拉松,当今中国最无耻的体育骗局》爆红,称“马拉松被包装成一种很酷的生活方式”,“长跑和马拉松运动员死于心血...
2026-02-06
2026-02-05
2026-02-05
2026-02-04
2026-02-04

